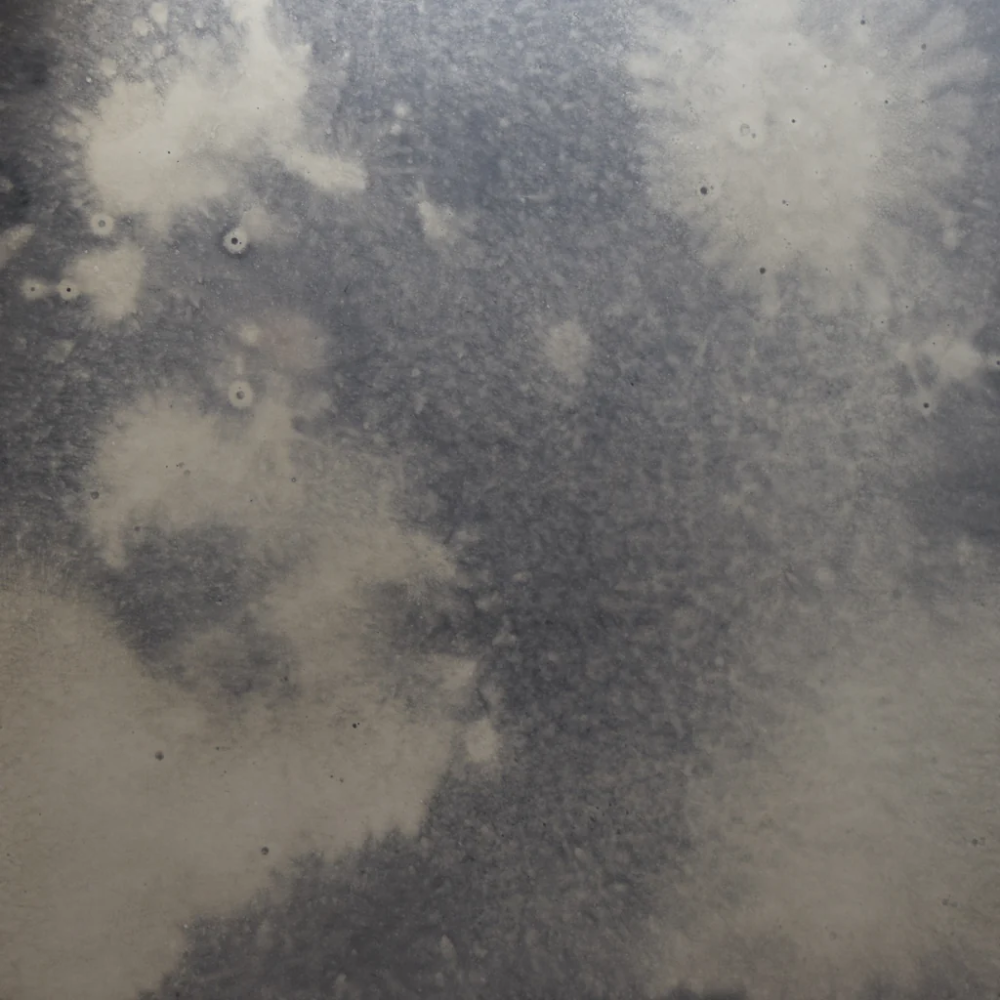

O dimensiune pentru fiecare cameră
Oricare ar fi dimensiunea camerei dvs., veți găsi la noi dimensiunea potrivită. O gamă largă de configurații vă permite să adaptați perfect dimensiunea la nevoile dumneavoastră.
Premium Line
Oglinzile luminoase Premium Line deschid o gamă largă de posibilități de a amenaja o baie modernă! Linia Premium constă din 19 decoruri diferite ale carcasei, care pot fi adaptate la mobilierul dvs. de baie. Linie premium concepută astfel încât lumina de fundal să fie îndreptată exact spre persoana care stă în fața oglinzii.

Recenzii
Nu există recenzii până acum.